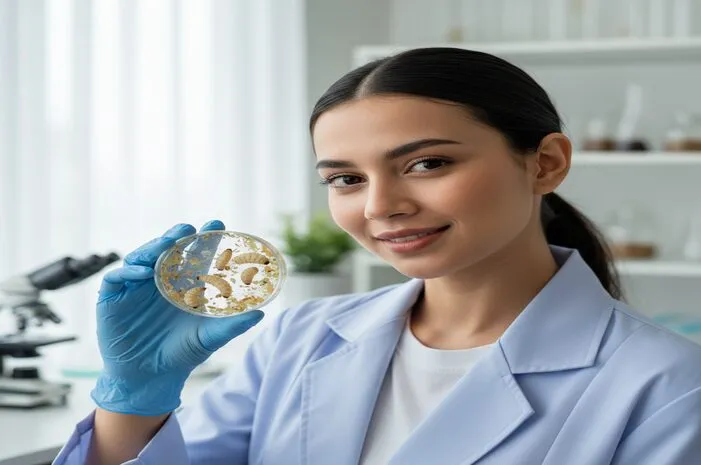
Maggot: Solusi Sampah Organik dan Pakan Ternak Kaya Gizi!

Maggot: Solusi Sampah Organik dan Pakan Ternak Kaya Gizi!
Maggot: Solusi Sampah Organik & Pakan Ternak Alami
Maggot mungkin terdengar menjijikkan, tetapi larva lalat Black Soldier Fly (BSF) ini memiliki peran penting dalam pengelolaan limbah organik dan sebagai sumber pakan alternatif. Artikel ini akan membahas secara mendalam tentang apa itu maggot, manfaatnya, serta potensinya dalam berbagai bidang.
Apa Itu Maggot?
Maggot adalah larva dari lalat Black Soldier Fly (BSF) atau Hermetia illucens. Bentuknya menyerupai belatung, berwarna putih keabu-abuan, dan berukuran kecil. Maggot dikenal karena kemampuannya dalam mengurai sampah organik dengan sangat cepat dan efisien.
Dalam siklus hidup lalat BSF, maggot merupakan fase larva setelah telur menetas. Setelah melewati fase larva, maggot akan berubah menjadi pupa dan kemudian menjadi lalat dewasa.
Manfaat Maggot yang Perlu Diketahui
Maggot memiliki berbagai manfaat, menjadikannya solusi yang menarik untuk berbagai permasalahan lingkungan dan ekonomi:
- Pengurai Sampah Organik: Maggot sangat efektif dalam mengurai sampah organik seperti sisa makanan, buah-buahan, dan sayuran. Proses penguraian ini dapat mengurangi volume limbah hingga 70% dalam waktu singkat.
- Pakan Ternak Alternatif: Maggot mengandung protein, lemak, dan asam amino esensial yang tinggi, sehingga sangat cocok sebagai pakan ternak untuk unggas, ikan, dan hewan peliharaan lainnya.
- Pupuk Organik: Sisa media budidaya maggot (kasgot) dapat digunakan sebagai pupuk organik yang kaya nutrisi untuk tanaman.
- Ramah Lingkungan: Budidaya maggot BSF tidak menimbulkan bau yang menyengat dan tidak membawa penyakit, berbeda dengan lalat rumah.
Maggot sebagai Solusi Pengelolaan Limbah Organik
Permasalahan limbah organik menjadi tantangan besar di berbagai kota besar. Maggot menawarkan solusi alami dan efektif untuk mengatasi masalah ini. Dengan kemampuannya mengurai sampah organik dengan cepat, maggot dapat mengurangi jumlah sampah yang berakhir di tempat pembuangan akhir (TPA).
Budidaya maggot dapat dilakukan di skala rumah tangga maupun industri. Prosesnya relatif sederhana dan tidak membutuhkan lahan yang luas. Hal ini menjadikan maggot sebagai solusi yang dapat diakses oleh berbagai kalangan.
Nilai Gizi Maggot untuk Pakan Ternak
Maggot kaya akan protein, lemak, dan asam amino esensial yang penting untuk pertumbuhan dan kesehatan hewan ternak. Kandungan nutrisi ini membuat maggot menjadi alternatif pakan yang menarik dan lebih berkelanjutan dibandingkan pakan konvensional.
Penggunaan maggot sebagai pakan ternak dapat mengurangi ketergantungan pada sumber pakan impor dan membantu meningkatkan kualitas pakan lokal. Selain itu, budidaya maggot juga dapat membuka peluang ekonomi baru bagi peternak.
Siklus Hidup Maggot BSF
Memahami siklus hidup maggot BSF penting untuk keberhasilan budidaya. Siklus hidup BSF terdiri dari empat tahap:
- Telur: Lalat BSF betina meletakkan telur di dekat sumber makanan organik.
- Larva (Maggot): Telur menetas menjadi larva atau maggot. Pada tahap ini, maggot aktif memakan sampah organik dan tumbuh dengan cepat.
- Pupa: Setelah mencapai ukuran maksimal, maggot akan berubah menjadi pupa. Pupa tidak makan dan mengalami metamorfosis menjadi lalat dewasa.
- Lalat Dewasa: Lalat BSF dewasa tidak makan dan hanya fokus pada reproduksi. Lalat betina akan mencari tempat untuk bertelur dan memulai siklus baru.
Siklus hidup BSF biasanya berlangsung sekitar 4-6 minggu, tergantung pada kondisi lingkungan dan ketersediaan makanan.
Kesimpulan dan Rekomendasi
Maggot adalah solusi inovatif dan berkelanjutan untuk mengatasi masalah limbah organik dan menyediakan sumber pakan alternatif yang kaya nutrisi. Dengan berbagai manfaat yang ditawarkan, budidaya maggot memiliki potensi besar untuk dikembangkan lebih lanjut.
Jika memiliki pertanyaan lebih lanjut mengenai kesehatan atau nutrisi, jangan ragu untuk berkonsultasi dengan dokter melalui aplikasi Halodoc. Unduh Halodoc sekarang untuk mendapatkan informasi kesehatan terpercaya dan terhubung dengan tenaga medis profesional.


